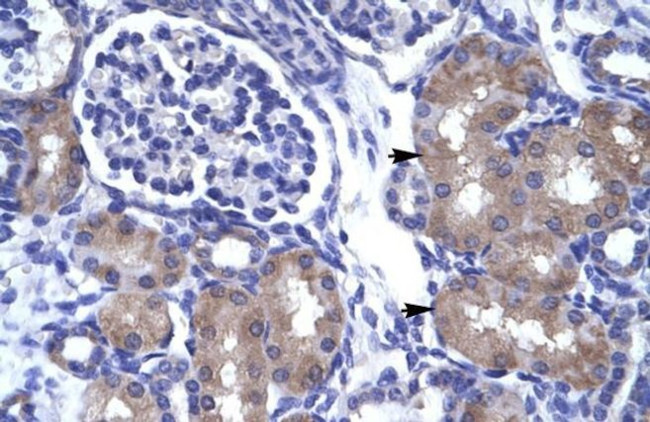
ASCL1 Antibody in Immunohistochemistry (IHC)

Search
Invitrogen
ASCL1 Polyclonal Antibody
{{$productOrderCtrl.translations['antibody.pdp.commerceCard.promotion.promotions']}}
{{$productOrderCtrl.translations['antibody.pdp.commerceCard.promotion.viewpromo']}}
{{$productOrderCtrl.translations['antibody.pdp.commerceCard.promotion.promocode']}}: {{promo.promoCode}} {{promo.promoTitle}} {{promo.promoDescription}}. {{$productOrderCtrl.translations['antibody.pdp.commerceCard.promotion.learnmore']}}




Please note: We are reviewing Western blot images included in the antibody testing data in our catalog, including those provided by third parties. Unless expressly labeled or annotated as “raw-unedited”, Western blot images included in the antibody testing data in our catalog may have been edited, optimized or otherwise adjusted for presentation.
产品信息
PA5-40527
种属反应
宿主/亚型
分类
类型
抗原
偶联物
形式
浓度
规格
纯化类型
保存液
内含物
保存条件
运输条件
RRID
产品详细信息
Peptide sequence: QSAQQQQQQQ QQQQQAPQLR PAADGQPSGG GHKSAPKQVK RQRSSSPELM
Sequence homology: Cow: 100%; Dog: 92%; Guinea Pig: 100%; Human: 100%; Mouse: 92%; Rabbit: 92%; Rat: 92%
靶标信息
ASCL1 (also known as ASH1) is a basic helix-loop-helix transcription factor that is required for early development of the nervous system. Expressed in fetal brain, ASCL1 is essential for the proper development of autonomic neurons and for the survival of subsets of autonomic neurons. ASCL1 interaction with MEF-2A may regulate the expression of specific genes that are critical for the formation of distinct neuronal circuits within the central nervous system. The high level of ASCL1 expression in neuroendocrine tumors, such as medullary thyroid cancer, small cell lung cancer and lung cancer with neuroendocrine features may provide a useful marker for cancers with neuroendocrine features. Mapping to human chromosome 12, the ASCL1 gene contains a trinucleotide repeat region, making this locus a candidate for inherited disease.
仅用于科研。不用于诊断过程。未经明确授权不得转售。
篇参考文献 (0)
生物信息学
蛋白别名: achaete scute protein; achaete-scute complex homolog 1; achaete-scute complex-like 1; Achaete-scute homolog 1; ASH-1; bHLHa46; Class A basic helix-loop-helix protein 46; KMT2H; unnamed protein product
基因别名: ASCL1; ASH1; BHLHA46; HASH1; MASH1
Entrez Gene ID: (Human) 429